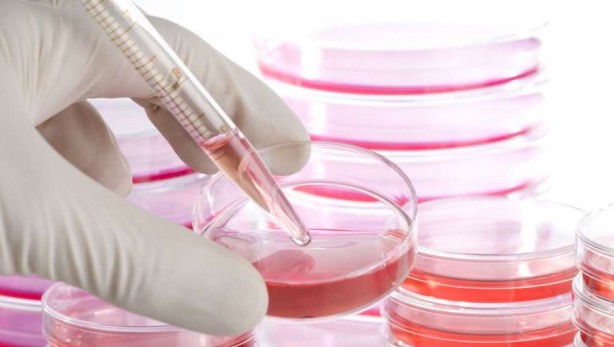
Foto - Parkinson hastalığı için umut doğdu

Parkinson hastalığı için umut doğdu
Parkinson hastalığı için yeni bir yöntem geliştiren bilim insanları kök hücre tedavisi yöntemiyle hastalığı tedavi edebilecek.
Parkinson hastalığı için yeni bir yöntem geliştiren bilim insanları kök hücre tedavisi yöntemiyle hastalığı tedavi edebilecek.
Kök hücre tedavisi ilk defa büyük bir başarıya imza atmak üzere. Embriyonik kök hücre tedavisi, bilimsel etik tartışmalarına rağmen önemli bir ivme kazandı. Buna göre seçilen 15 Parkinson hastasına laboratuvar ortamında kök hücreden üretilmiş hücreler hastalıklı hücrelerin yerini aldı. İlk ortaya çıkan sonuçlara bakılırsa hastalarda Parkinson hastalığında kök hücre tedavisi sonrası gerilemeler görülmeye başladı.
Parkinson hastaları için Embriyonik kök hücre tedavisi umudu Araştırmacılar, geleceğin tıp tedavi yöntemleri arasında görülen embriyonik kök hücre için oldukça tartışmalı bir yöntem kullanıyor.
Buna göre tüp bebeklerden alınan kök hücre örnekleri laboratuvar ortamında üretiliyor. California Üniversitesi’nden Nörolog Claire Henchcliffe’in de başı çektiği araştırmacılar, Parkinson hastalığı tedavisi için umut olacak sonuçlara ulaştı.
Buna göre araştırmacılar tüp bebek embriyolardan elde edilen kök hücreleri, Parkinson hastalarının dopamin hormonu üretemeyen hücreleriyle değiştirdi.
Parkinson hastalarında dopamin üretimi duran bu hücreler, hareket eksikliği gibi sorunlara neden oluyor.
Araştırmacılar ise laboratuvar ortamında üretilen nöron hücreleri ile bu eksiği giderdiklerini iddia ediyor. Ancak sonuçları yeterince başarılı bulmayan bilim insanları da mevcut.
Ancak araştırmanın Bayer’in bir yan kuruluşu olan BlueRock Therapeutics’in desteğine sahip olması önemli güvenceler arasında gösteriliyor.
Araştırmanın en önemli başarılarından biri ise laboratuvar ortamında üretilen bu beyin hücrelerinin sinapslar aracılığıyla kendini vücudun parçası gibi gösterebilmeleri.
Hücre üretiminde bu sınırın başarılı bir şekilde aşılması gelecekte başka hastalıkların tedavisi için de kök hücre tedavisinin önünü açma ihtimali yüksek.
WhatsApp İhbar Hattı
+90 (553) 313 94 23